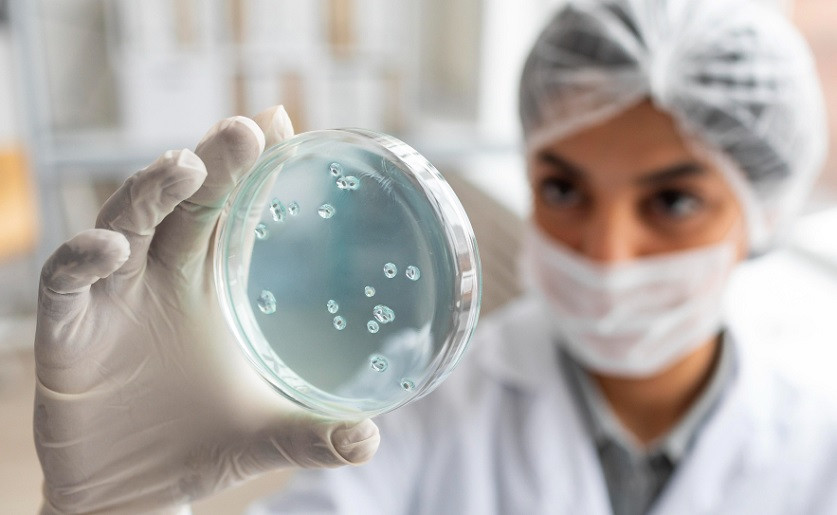

Η ισπανική αστυνομία κατέσχεσε δύο τόνους κοκαΐνης – Ήταν κρυμμένοι σε ιστιοπλοϊκό

 Newsbeast.gr
Newsbeast.gr
Η ισπανική αστυνομία κατέσχεσε περίπου δύο τόνους κοκαΐνης, αξίας 70 εκατομμυρίων ευρώ, από ένα ιστιοπλοϊκό το οποίο εντοπίστηκε να πλέει στα ανοιχτά των βόρειων ακτών της χώρας. Η περιοχή όπου εντοπίστηκε το σκάφος, ο Βισκαϊκός Κόλπος, είναι ασυνήθιστη γιατί συνήθως τα περισσότερα φορτία κοκαΐνης από τη Λατινική Αμερική προς την Ευρώπη κατευθύνονται προς τα δυτικά παράλια της Ισπανίας στον Ατλαντικό. Το σκάφος Night Falls, μήκους 13 μέτρων, έφερε σημαία Βρετανίας. Εντοπίστηκε και κατασχέθηκε ενώ απείχε περίπου 30 ναυτικά μίλια από την πόλη Σανταντέρ. Τα τέσσερα μέλη του πληρώματος, ένας Ισπανός, ένας Κολομβιανός και δύο Βενεζουελάνοι, συνελήφθησαν σύμφωνα με το Αθηναϊκό Πρακτορείο Ειδήσε
21:00 02/08/2023